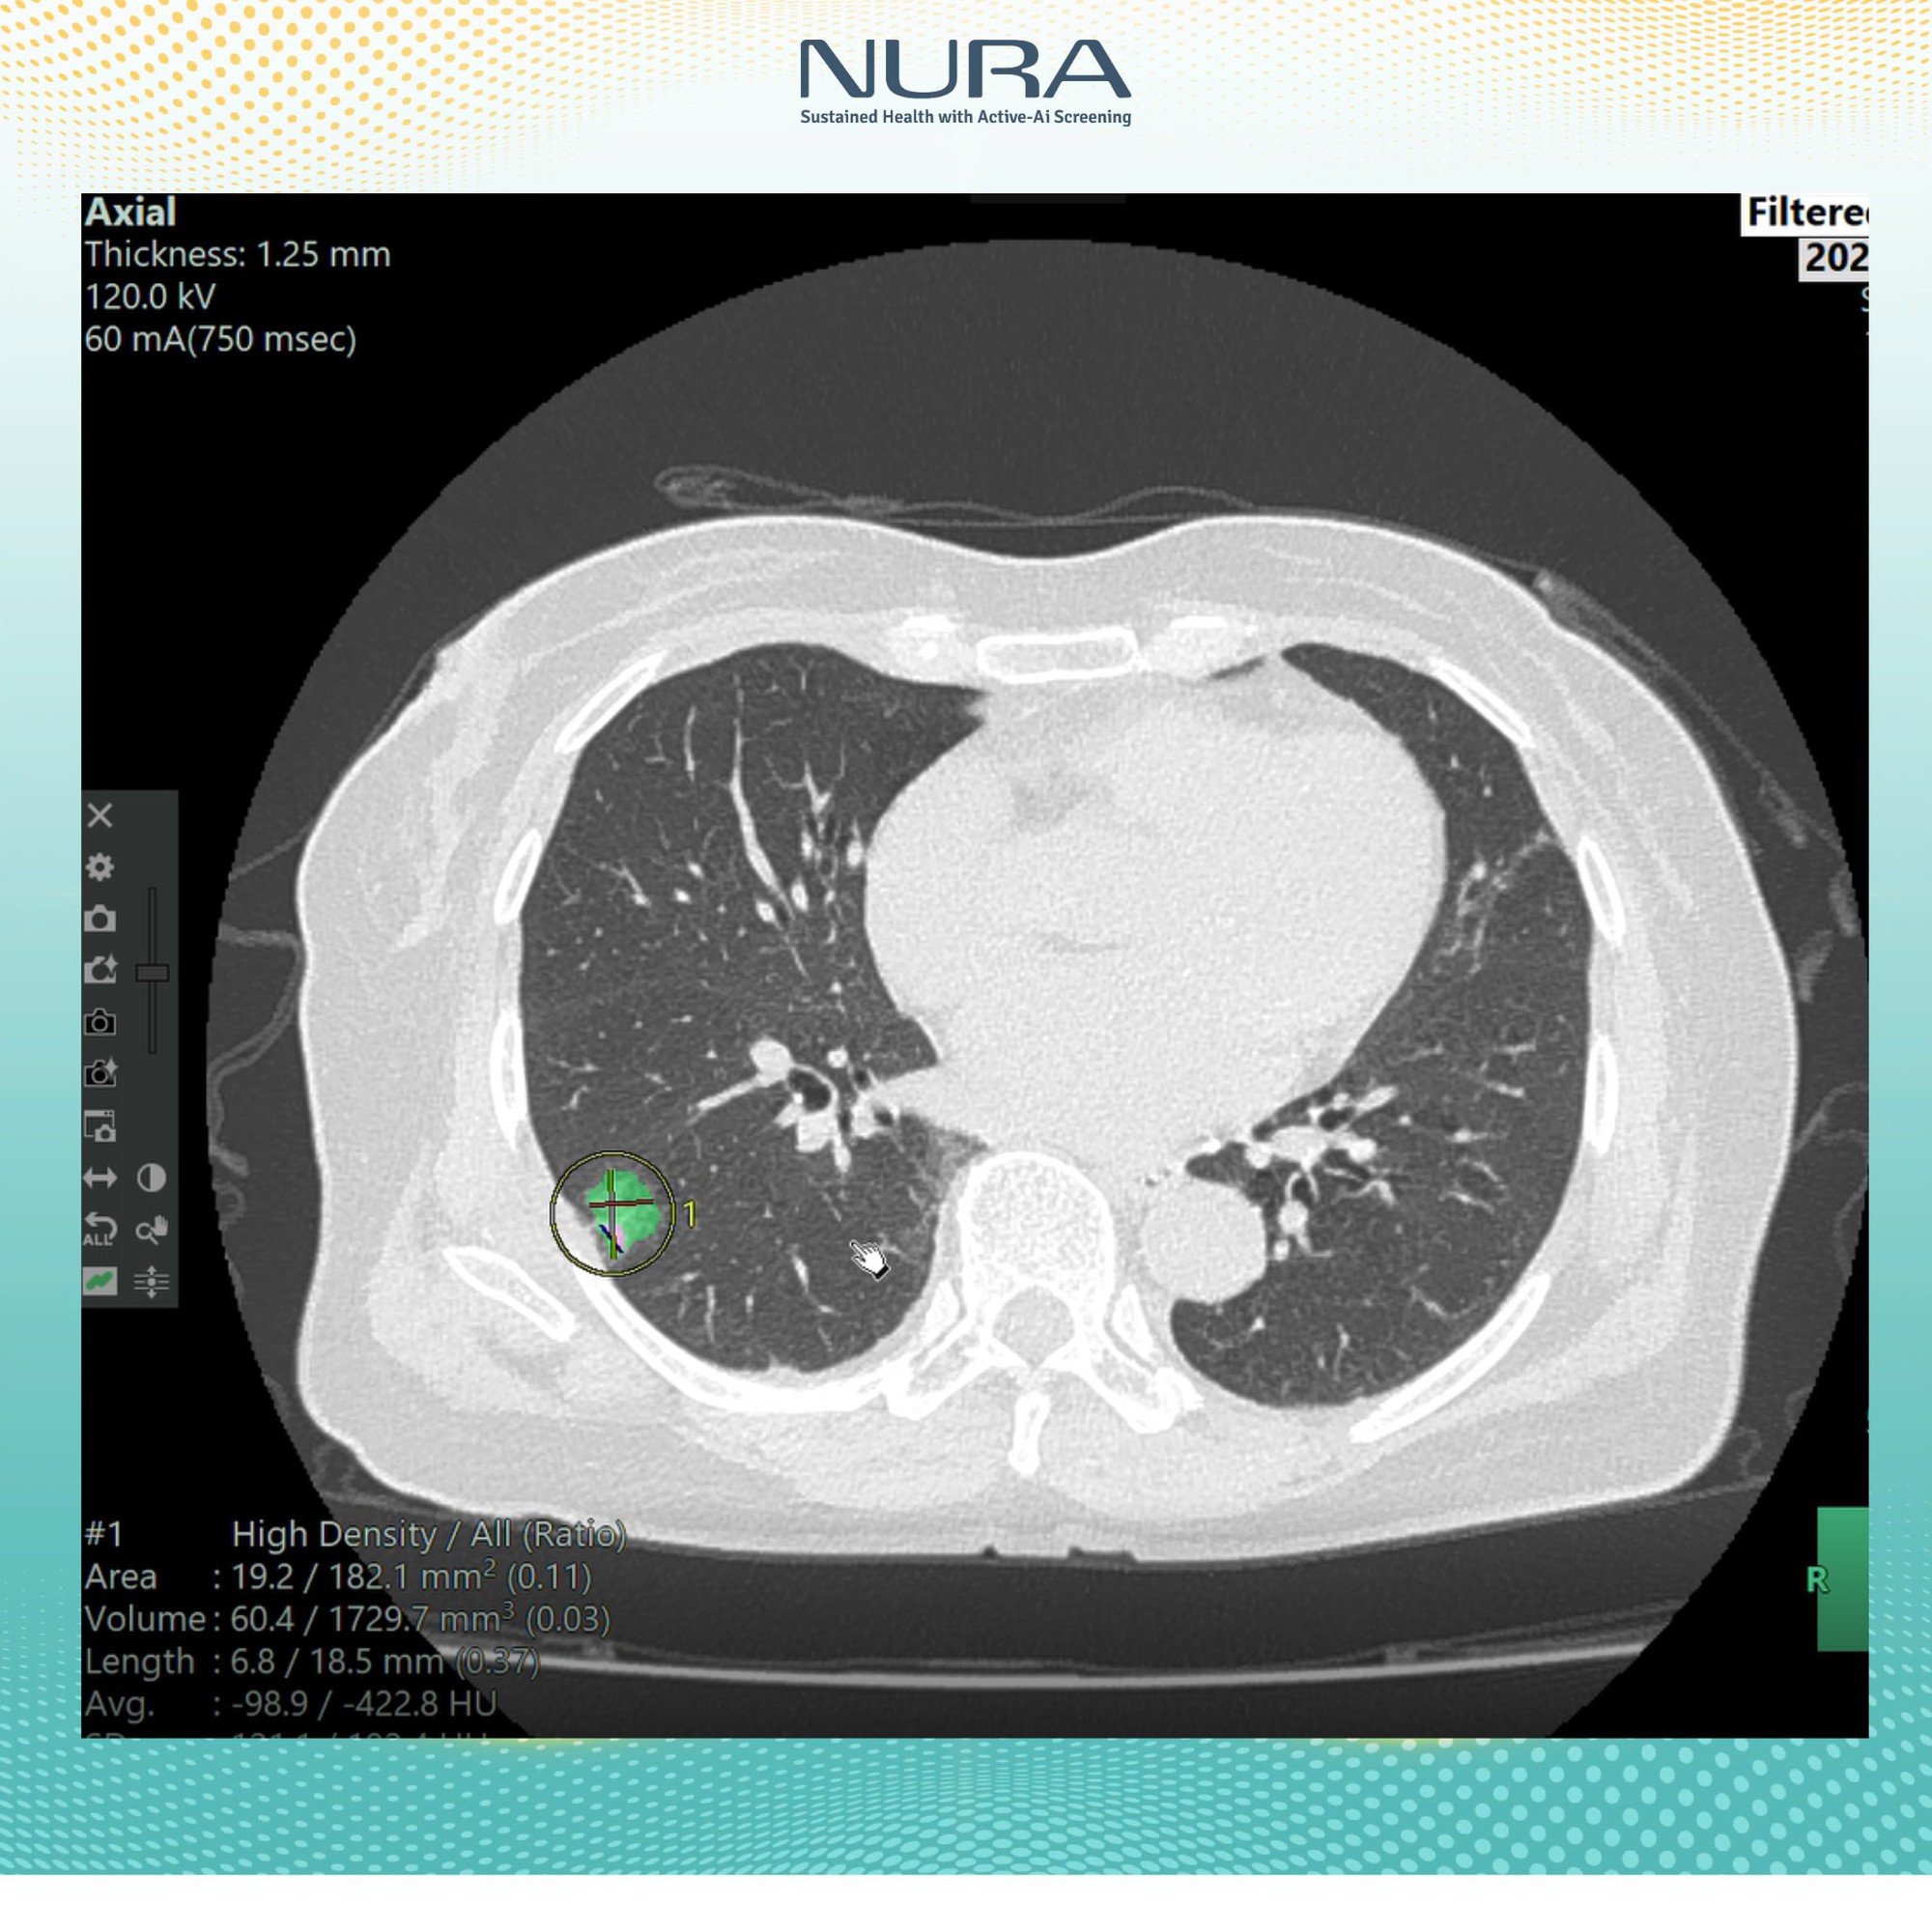

Trong số các thiết bị nổi bật tại trung tâm, máy chụp CT tại đây đã được các bác sĩ Nhật Bản công nhận là “chìa khóa vàng” trong tầm soát phát hiện ung thư. Được vận hành bởi đội ngũ bác sĩ giàu kinh nghiệm và tích hợp AI, hệ thống máy chụp này không chỉ giúp phát hiện các tổn thương rất nhỏ mà còn đảm bảo an toàn tối đa cho người được thăm khám.

Máy chụp CT tại Trung tâm Tầm soát Công nghệ cao NURA được các bác sĩ Nhật Bản đánh giá là “thìa khoá vàng” trong tầm soát phát hiện ung thư
“Công nghệ AI của NURA không chỉ đơn thuần là công cụ hỗ trợ, mà còn đóng vai trò quan trọng trong quy trình phân tích và nhận diện hình ảnh. Bằng cách thu thập và xử lý dữ liệu hình ảnh y khoa từ hơn 400 triệu ca bệnh được Fujifilm Nhật Bản lưu trữ trong suốt 10 năm, AI có thể nhận diện sớm các tổn thương bất thường – từ những nốt nhỏ nhất, kích thước từ 1mm trở lên.
Tại NURA, công nghệ AI được xây từ 400 triệu bộ dữ liệu hình ảnh và tích hợp trong hệ thống tầm soát công nghệ cao, cho phép lưu trữ và phân tích dữ liệu hình ảnh rõ nét, vượt trội so với phương pháp chụp cắt lớp truyền thống”, Đại diện NURA chia sẻ với báo chí.
Chỉ trong vòng 8 tháng kể từ khi ra đời, Trung tâm Tầm soát Công nghệ cao NURA đã nhanh chóng khẳng định được vị thế mình khi nơi đây tiếp đón gần 9.000 lượt khách đến thăm khám. Đáng chú ý, có đến 65% khách hàng thăm khám tại NURA phát hiện ra các bất thường về sức khỏe, từ đó có thể chủ động điều trị hoặc theo dõi sát sao, tránh diễn tiến bệnh nặng.
Máy chụp CT tại NURA được thiết kế để giúp quá trình tầm soát diễn ra thoải mái nhất có thể. Lỗ giàn máy của NURA (lỗ hổng mở trong máy CT – PV) lớn hơn các máy khác để giảm cảm giác sợ hãi và lo lắng của khách hàng. Đặc biệt, phòng chụp CT tại NURA được trang bị công nghệ tiên tiến nhất, đảm bảo không chỉ giúp chẩn đoán chính xác mà còn giảm thiểu tối đa bức xạ lên đến 97%, bảo vệ sức khỏe người bệnh. Bởi vậy, mọi người không cần phải tiêm thuốc cản quang trước khi chụp.

Quá trình chụp CT tại Nura được chia làm hai lần:
- Lần thứ nhất để đo điểm vôi hóa động mạch vành và tim, giúp sàng lọc sớm nguy cơ bệnh tim mạch.
- Lần thứ hai là chụp lồng ngực và ổ bụng, hỗ trợ phát hiện các tổn thương dù là từ 1mm tại phổi, gan, tụy, thận và các cơ quan quan trọng khác.
“Chúng tôi sử dụng công nghệ tái tạo 3D tiên tiến nhất, giúp mở rộng phạm vi bao phủ và tăng tốc độ quét, đảm bảo hiệu quả và độ chính xác cao trong từng hình ảnh. Máy chụp CT hoạt động với tốc độ cao, bạn sẽ chỉ cần nín thở trong khoảng 7–8 giây, lắng nghe và làm theo hướng dẫn phát ra từ hệ thống loa tự động”, BS. Nguyễn Hải Anh – Giám đốc chuyên môn của Nura cho biết.
Chỉ sau vài phút, kết quả sẽ được gửi về dưới dạng các hình ảnh cắt lớp chi tiết. Những lát cắt này cho phép bác sĩ phát hiện các tổn thương có kích thước từ 1mm, giúp việc chẩn đoán trở nên chính xác và nhanh chóng hơn rất nhiều.

Quy trình tại đây diễn ra nhanh chóng, gọn gàng và hoàn toàn nhẹ nhàng. Chỉ trong vòng khoảng 5 phút, cả hai lần chụp CT đã được hoàn tất mà không hề gây ra cảm giác khó chịu hay lo lắng.
Sau khi thực hiện xong quy trình chụp CT, khách hàng được đưa đến các phòng khác theo gói dịch vụ tầm soát. Mọi thao tác đều được diễn ra nhanh chóng. Chỉ trong vòng gần 60 phút, khách hàng đã hoàn tất tầm soát toàn diện.
Chia sẻ với chúng tôi, BS. Nguyễn Hải Anh – Giám đốc chuyên môn của Nura cho biết, việc áp dụng công nghệ AI trong việc tầm soát ung thư có ba ưu điểm vượt trội hơn so với truyền thống đó là an toàn, nhanh chóng và chính xác.
- Về tính an toàn: Công nghệ chụp CT tại NURA sử dụng liều tia cực thấp – giảm tới 97% so với mức thông thường. Nhờ đó, nguy cơ phơi nhiễm bức xạ được hạn chế tối đa, đảm bảo an toàn cho khách hàng, đặc biệt là những người cần tầm soát định kỳ.
- Về tính thuận tiện: Chỉ trong vòng chưa đầy 10 phút, khách hàng có thể thực hiện 6 phim chụp CT để tầm soát các bệnh lý ung thư tại phổi, gan, thận, tụy, cổ tử cung và vú. Tốc độ này giúp tiết kiệm thời gian mà vẫn đảm bảo chất lượng ảnh chụp.
- Về tính chính xác: AI không chỉ giúp phát hiện tổn thương từ rất sớm, mà còn tự động đo kích thước từng nốt nghi ngờ, đếm số lượng, đánh giá mức độ nguy cơ và hỗ trợ bác sĩ trong việc đưa ra quyết định chuyên sâu.
Phát hiện khối u vú 10mm bị bỏ sót cho bệnh nhân có siêu âm định kỳ hàng năm
Một trường hợp bệnh nhân nữ đã thực hiện siêu âm tuyến vú đều đặn mỗi năm trong thời gian dài tới tầm soát 14 bệnh ung thư và 22 bệnh lối sống tại Nura. Kết quả chụp nhũ ảnh (Mammography) được trí tuệ nhân tạo AI phát hiện một khối u kích thước 10mm ở ngực trái.


Nhìn trên kết quả chụp nhũ ảnh, bằng mắt thuờng rất dễ bỏ sót khối u này bởi sự khác biệt giữa mô bất thường và mô lành tính hầu như không đáng kể. Điều này cho thấy việc thực hiện tầm soát định kỳ không có nghĩa là bạn có thể phát hiện bệnh sớm. Tầm soát không chỉ cần “đúng lịch”, định kỳ, mà còn cần “đúng phương pháp” đi kèm với thiết bị hiện đại.
“Chậm một chút thôi, có lẽ tôi đã không còn cơ hội tự đứng trên đôi chân của mình”
Là một trong những khách hàng từng thăm khám tại Trung tâm Tầm soát Công nghệ cao NURA, chị Phan Hoàng Phong Thu – Phó Tổng Giám đốc Công ty Crystal Bay Card – chia sẻ rằng chỉ vài tháng trước, chị suýt bị liệt nửa người do một khối u tủy sống. May mắn thay, nhờ phát hiện sớm và can thiệp kịp thời, chị đã vượt qua được biến cố nghiêm trọng này.
Chị Thu chia sẻ, chị làm việc ở văn phòng và đã trải qua hai lần sinh nở, từng quen với những cơn đau lưng âm ỉ, tê bì chân tay, đôi khi lan lên tận cổ và vai gáy. Chị cho rằng đó là những triệu chứng bình thường, hệ quả tất yếu của việc sinh nở và tính chất công việc phải ngồi nhiều giờ liền. Bởi vậy chị chủ quan, chưa từng nghĩ đến việc kiểm tra sức khỏe chuyên sâu.
Đến khi nhận thấy sức khoẻ ngày càng suy giảm, những cơn đau âm ỉ thường xảy xuyên hơn, chị mới quyết định đi khám sức khoẻ. Theo lời giới thiệu của một người bạn, chị tìm đến Trung tâm Tầm soát Công nghệ cao NURA để kiếm tra.
Kết quả thăm khám ban đầu cho thấy hầu hết chỉ số của chị đều trong giới hạn bình thường. Tuy nhiên, bác sĩ phát hiện một bất thường nhỏ: một nang ở khu vực đốt sống.
“Tôi không có nhiều kiến thức về y khoa nên chỉ nghĩ đó là vấn đề đơn giản”, chị Thu nói.
Sau khi thăm khám, bác sĩ tại NURA đã khuyên chị nên đến bệnh viện tuyến trên để kiểm tra sâu hơn bằng các phương pháp hiện đại như chụp cộng hưởng từ (MRI). Ngay trong tuần đó, chị Thu đến Bệnh viện E để thực hiện các theo lời khuyên của bác sĩ NURA.
Kết quả MRI đã thay đổi hoàn toàn suy nghĩ của chị. Nang đốt sống hóa ra là một khối u tủy thần kinh kích thước lớn, có thể đã âm thầm phát triển gần 10 năm nay.
“Bác sĩ bảo khối u đã chèn ép dây thần kinh gây ra nhiều triệu chứng nghiêm trọng. Nếu không can thiệp kịp thời sẽ ảnh hưởng rất nghiêm trọng đến sức khoẻ và rất có thể tôi sẽ phải đối mặt với nguy cơ teo cơ hoặc liệt chi dưới”, chị Thu kể.
Chị Thu nhanh chóng đồng ý đăng ký phẫu thuật, loại bỏ khối u. Sau nhiều giờ đồng hồ, ca phẫu thuật diễn ra thành công tốt đẹp.
“Tôi cảm thấy rất may mắn khi biết đến NURA. Nhờ kiểm tra tầm soát toàn diện nhanh chóng tại trung tâm mà tôi có thể biết được sức khoẻ của mình thế nào. Từ đó, tôi có thể sớm phát hiện bệnh và điều trị kịp thời”, chị Thu nói thêm.



Một số hình ảnh khách hàng đánh giá về chất lượng dịch vụ tại NURA






